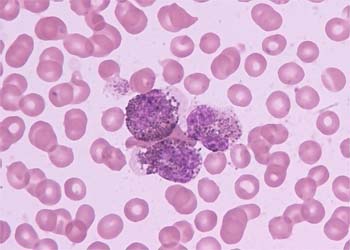

白血病治疗新突破:“微移植”患者生产率高费用低
记者昨日从解放军307医院获悉,该院全军血液病及放射病研究所所长艾辉胜带领团队采用微移植治疗白血病,患者6年生存率达80%以上,且移植费用仅为传统移植的1/3。其研究论文《微移植:急性髓性白血病缓解后治疗》在美国权威期刊《临床肿瘤学杂志》发表,引起了国际权威专家高度评价,称微移植是“分离移植物抗肿瘤效应和移植物抗宿主病的新模式”。
据艾辉胜所长介绍,与传统的造血干细胞移植相比,“微移植”无需在移植前对患者进行大剂量的放疗和化疗,只需使用小剂量化疗药杀死患者体内癌细胞,再将改造后的供者造血干细胞移植到患者体内。因改造后的造血干细胞提高了抗白血病的功能,同时减小了抗排异反应,所以当这些造血干细胞进入患者体内后,不会被患者所排异,无移植相关并发症发生,具有抗白血病作用强、造血恢复快,安全简便的好处。
另外,微移植不受病人年龄和配型限制,解决了很多患者找不到配型成功的捐献者的问题。
文章由福冠堂新特药在线(www.fuguantang.com)整理发布
相关文章
最新资讯
热门药品